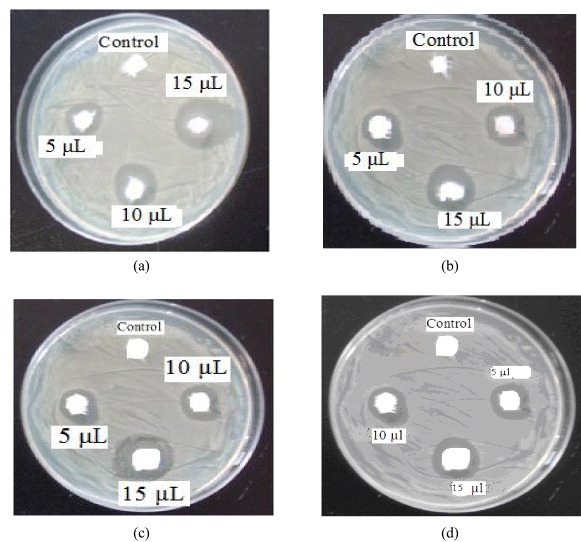
Figure 7

Abstract
The rapid one-pot synthesis of silver nanoparticles (SNPs) at room temperature by using hydrazine hydrate as reducing agent and polyvinyl alcohol as stabilizing agent is reported. The SNPs were characterized with UV-visible (UV-Vis) spectroscopy, x-ray diffraction (XRD), field emission scanning electron microscopy (FE-SEM), atomic force microscopy (AFM) and transmission electron microscopy (TEM). The synthesized silver nanoparticle shows surface plasmon resonance at 410 nm. The XRD reveals face-centered cubic (FCC) structure of SNPs. FE-SEM, AFM and TEM show that nanoparticles have spherical morphology with diameters in the range of 10–60 nm. The antimicrobial activity of synthesized hybrid material against strains of four different bacteria (Bacillus cereus, Escherichia coli, Staphylococus aureus, Proteus vulgaris), that are commonly found in hospitals has been studied. The results indicate that such particles have potential applications in biotechnology and biomedical science.
Export citation and abstract BibTeX RIS

Content from this work may be used under the terms of the Creative Commons Attribution-NonCommercial-ShareAlike 3.0 licence. Any further distribution of this work must maintain attribution to the author(s) and the title of the work, journal citation and DOI.
1. Introduction
Nanotechnology has become one of the most interesting areas of scientific research in recent years, particularly in the area of material research, including the synthesis, characterization and application of nanometer-sized metals, oxides, semiconductors and ceramics [1]. Nanoparticles exhibit electronic and optical properties different from those displayed by their bulk-material counterparts. These properties can further be tuned by altering the dimensions and their mutual interactions [2–5]. Silver nanoparticles (SNPs) have been found to have applications in various fields such as intercalation of materials for electrical batteries [6], optical receptors [7], polarizing filters, catalysts in chemical reactions, bio-labelling [8], sensors [9], bioactive materials [10], signal enhancers in SERS-based enzyme immunoassay [11] and antimicrobial agents [12]. The antimicrobial property of silver is being exploited in the biomedical field [13]. The significant feature of silver is its broad spectrum antimicrobial property which is due to microbial colonization associated with biomaterial related infections [14]. Silver nanoparticles in the form of silver paste can be applied to electrodes due to its conductivity. Silver nanodispersion is used in conductive filler [15]. For synthesis of highly dispersed metallic nanoparticles, a wide range of reducing agents has been used [16, 17]. These nanoparticles are stabilized by a variety of different capping agents such as thiols, amines and polymers (e.g. polyvinyl pyrrolidone PVP) [18]. The synthesis of silver nanoparticles by chemical route controls particle size, particle shape and morphology [19]. Polyvinyl alcohol (PVA) is a bio-friendly polymer since it is water soluble and has extremely low cytotoxicity. This allows a wide range of potential biomedical applications. It is used as a stabilizer due to its optical clarity which enables investigation of nanoparticle formation. Also, introduction of nanosized silver into PVA matrix provides antibacterial activity, which is highly desired in textiles used in medical clothing and household products [20].
Silver in colloidal state has germicidal properties and has shown negligible toxicity even at high concentrations [21, 22]. Silver nanoparticles are ideal for spectral interrogation of various biological interactions [23, 24] and for use as tags to indicate location and environment of a target of interest. Current research in bactericidal nanomaterial has opened a new era in pharmaceutical industries. Silver nanoparticles are the metal of choice as they hold the promise to kill microbes effectively [25]. Panacek et al have studied the antibacterial activity of silver colloid with different size distribution and, according to them, 25 nm sized nanoparticles were most effective.
In this paper, we describe the synthesis of PVA-capped SNPs in water. It has been shown that fine dispersion of silver nanoparticles can be achieved. UV-Vis absorption spectra are used to monitor morphological evolution of silver nanoparticles.
2. Experimental
2.1. Materials
All chemicals, silver chloride, polyvinyl alcohol, hydrazine hydrate, ammonia, were of AR grade, purchased from Sigma Aldrich and used without further purification. All solutions were prepared in double distilled water.
The nutrient agar, type 1 agar and sodium chloride was purchased from Hi-media. These agars were used to grow and maintain the bacterial culture.
2.2. Synthesis of SNPs
In typical synthesis, 25 ml solution of 0.01 M silver chloride was prepared in double distilled water and taken in Erlenmeyer flask. The solution was maintained between pH 8–9 by ammonia. To this solution, 20 ml, 2% polyvinyl alcohol dissolved in distilled water was added with constant stirring. 1 ml 0.1 M solution of hydrazine hydrate was added drop wise. The reduction of silver chloride takes place to produce SNPs colloid. The colloidal solution was analyzed by UV-Vis spectroscopy, Shimadzu UV-Vis near infrared (NIR) spectrophotometer (model-3600) by using distilled water as [26]. The absorption spectra were recorded with radiation wavelength between 250 and 600 nm.
XRD pattern were measured using CuKα radiations (λ=1.54 Å) on Bruker AXS D8. The microstructure of the prepared sample was mapped by FE-SEM (JSM-6160) at room temperature. The morphological characterization of synthesized SNPs was studied by using AFM (Agilent Technology) in contact mode. The size and morphology was determined by TEM. TEM observations were performed on Philips CM-200 operated at accelerating voltage 20–200 kV with resolution 2.4 Å. Particle size of synthesized silver nanoparticles was analyzed through dynamic light scattering. Light-scattering measurements were carried out at 90° on a photon correlation spectrometer (PCS)—Zetasizer 3000 HAS equipped with a digital autocorrelation from Malvern Instruments UK.
2.3. Assays for minimum inhibitory concentration of SNPs
The synthesized SNPs were used in bactericidal study against different bacterial strains. The bactericidal tests were performed with bacterial strains as bacillus cereus (B. cereus), Escherichia coli (E. coli), Staphylococcus aureus (S. aureus), Proteus vulgaris (P. vulgaris). Nutrient agar and type-I agar were used as media to grow bacteria. The bacterial solution was prepared in 0.86% saline. The antibacterial activity of silver nanoparticle sample was assayed by following standard well diffusion technique. The bacterial suspension was spread on nutrient agar in Petri plate to create confluent lawn of bacterial growth. The wells of 6 mm were prepared by borer. The solutions of different SNP concentrations (5, 10 and 15 μl) were poured into each well. The well without silver nanoparticles was treated as control (water and PVA). These plates were incubated for 24 h at 35 ° C. The lowest concentration at which the Petri plate did not show any visible growth after microscopic evaluations was considered as minimum inhibitory concentration (MIC). The susceptibility of test organisms was determined after 24 h by measuring zone of inhibition around each well. In control no zone of inhibition was observed. This proves that the antimicrobial activity is due to silver nanoparticles. All antimicrobial parameters have been determined in triplicate.
3. Results and discussion
Reduction reaction of silver chloride in presence of PVA is shown below:

The UV-Vis spectroscopy was used to follow the reaction process and to characterize the optical properties of the nanoparticles. The as-prepared PVA-capped SNPs show a surface plasmon resonance (SPR) absorption peak at 410 nm (figure 1(a)). The synthesis of silver nanoparticles as a function of the concentration of silver chloride and PVA and as a function of time was studied by UV-Vis spectroscopy (figures 1(b)). Figure 1(a) shows PVA-capped SNPs produced from solution. A peak centered at ∼410 nm is due to the surface plasmon resonance of silver nanoparticles. This value is in good agreement with the literature reports on the spectrum of silver nanoparticles in aqueous solutions. The position and shape of plasmon absorption of noble metal nanocluster is strongly dependent on size, shape, dielectric medium surface absorbed species and surrounding matrix [27, 28].
Figure 1 UV-Vis spectra of silver nanoparticles (a) showing SPR band, (b) synthesized with different silver chloride concentrations, concentration of PVA is 1%, (c) synthesis with different PVA concentrations, concentration of silver chloride is 0.01 M, (d) synthesis with different reaction times, concentrations of silver chloride and PVA are 0.01 M and 1%, respectively.
Figure 1(b) shows UV-Vis spectra of SNPs prepared with different silver chloride concentrations. The SPR at approximately 410 nm was consistent with SNPs. It can be seen that the intensity of plasmon maxima increases as a function of increase in the silver chloride concentration from 0.001 to 0.009 M, suggesting an increase in the concentration of SNPs. It is important to note that although the silver chloride concentration is increased, the particle size does not increase, possibly due to the capping action of PVA.
Figure 1(c) shows the influence of PVA concentration on synthesis of SNPs. The SPR peak is slightly red shifted by 5 nm. PVA plays an important role in the synthesis of SNPs, by preventing them from aggregation. It is important to note that PVA as a protective agent plays a decisive part in controlling size distribution of SNPs. However, increasing the concentration of PVA does not lead to the reduction of silver nanoparticle size.
Figure 1(d) shows UV-Vis spectra of SNPs as a function of reaction time. From the absorption spectra it is clear that, Ag + ions are immediately reduced after the addition of hydrazine hydrate and hence there is not much effect on particle size during the period from 10 min to 24 h. As we increase time from 10 min to 24 h, the number of SNPs goes on increasing because hydrazine gradually reduces silver ions to SNPs as time passes. Furthermore, to get closer insights into SNPs formation, some kinetic parameters of this process should be evaluated. Effectively, from the formal kinetic point of view, Ag + reduction by hydrazine hydrate can be described by the following equation

where k is the rate constant, [Ag +] is the silver ion concentration and n is the reaction order.
Figure 2 shows XRD pattern of SNPs deposited on glass plate. All prominent peaks at respective 2θ values are known for zero valent FCC silver, representing (111), (200), (220) and (311) crystal planes due to Braggs reflection at 2θ=38.06 °, 44.24 °, 64.66 ° and 77.43 ° (JCPDS No 04-0783). XRD line broadening was used for the analysis of crystallite size using Scherrer formula

Figure 2 XRD pattern of silver nanoparticles at 0.01 M of silver chloride.
The average particle size was found to be about 17 nm. The lattice constant calculated from this pattern is in agreement with the published results.
Figure 3 shows FE-SEM images of SNPs at different concentrations of silver chloride: 0.005, 0.007, 0.009 and 0.01 M. The SNPs were deposited on glass substrate by drop coating and used as the sample for FE-SEM analysis. The spherical nanoparticles uniformly distributed on glass substrate show average diameter of 10–50 nm. Particle size slightly increases with increasing concentration of silver chloride from 0.005 to 0.01 M.
Figure 3 FE-SEM image of SNPs with different silver chloride concentration (a) 0.005 M, (b) 0.007 M, (c) 0.009 M and (d) 0.01 M.
The topography and morphology of SNPs were studied by using AFM (figure 4). It was noticed that the SNPs were regularly arranged on a glass slide obtained by drop coating. Particle size of SNPs was measured and found in the range 10–50 nm. Figures 4(a) and (b) show two-dimensional and three-dimensional AFM images of SNPs at 0.005 M silver chloride concentration.
Figure 4 Two-dimensional (a) and three-dimensional (b) AFM images of SNPs at 0.005 M silver chloride concentration.
Figures 5(a) and (b) show two-dimensional and three-dimensional AFM images of SNPs at 0.01 M silver chloride concentration.
Figure 5 Two-dimensional (a) and three-dimensional (b) AFM images of SNPs at 0.01 M silver chloride concentration.
TEM image clearly demonstrates that the SNPs were spherical or pseudo-spherical (figures 6(a) and (b)), polydispersed, with more or less uniform size ranging from 10 to 60 nm as dynamic light scattering using a Malvern zetasizer was used to determine the particle size distribution of the particles in solution. This is in agreement with the TEM data as shown in the particle size distribution, illustrated by the histogram (figure 6(c)). The selected area electron diffraction (SAED) micrograph of SNPs (figure 6(d)). shows FCC crystalline structure with indexed diffracting planes [29].
Figure 6 (a) TEM micrograph of PVA capped SNPs at 0.01 M concentration; (b) representative high resolution TEM image of PVA-capped SNPs; (c) histogram showing particle size distribution of SNPs; (d) selected area electron diffraction (SAED) micrograph of SNPs.
The as-synthesized SNPs were studied for their anti-bacterial activity (figure 7). The minimum inhibitory concentration (MIC) is the lowest concentration at which a tested compound can respectively inhibit bacterium growth more than 99%. The MIC of SNPs and antibacterial study of different bacterial strains was studied by exposing bacterial strains to SNPs. The different concentrations 5, 10 and 15 μl were maintained, which shows a remarkable zone of inhibition (figures 7(a)–(d)).
Figure 7 Zone of inhibition (antimicrobial effect) by SNPs (a) on B. cereus; (b) on E. coli; (c) on S. aureus; (d) on P. vulgaris.
The various tested concentrations produce inhibitions of 10, 15, 20 mm for B . cereus, 10, 20, 25 mm for E. coli, 3, 5, 11 mm for S. aureus and 5, 20, 20 mm for P. vulgaris. This vast difference in zone of inhibition may be due to the susceptibility of the organism used in the present study. The above results were obtained for 5, 10 and 15 ppm, respectively. The maximum antibacterial activity was recorded for E. coli and B. cereus. The zone of inhibition increases with increase in concentration of SNPs. The control shows no zone of inhibition, which indicates that bactericidal activity is exclusively due to SNPs (figure 7, table 1). These results can be interpreted on the basis of the possible mechanisms, all emphasizing the dependence of all antibacterial action of SNPs on their size, dose, and morphology. Effectively, different mechanisms for bacterial action of silver NPs are the following: (i) Ag + ions are supposed to bind to sulfhydryl groups, which leads to protein denaturation by the reduction of disulfide bonds; (ii) Ag + can complex with electron donor groups containing sulfur, oxygen, or nitrogen that are normally present as thiols or phosphates on amino acids and nucleic acids. Also, SNPs have been found to attach to the surface of the cell membrane and disturb its function, penetrate into bacteria, and release Ag 0; (iii) SNPs target the bacterial membrane, leading to a dissipation of the proton motive force. Thus, a decrease in the NPs' size can lead to an increase in the specific surface of a bactericidal specimen, inducing an increase in their ability to penetrate the cell membrane, and thus improving antibacterial activity. It is also reported that silver nanoparticles with size range of 1–10 nm attach to the cell membrane and drastically disturb its proper function, like permeability and respiration. Further, upon penetration, more damage is caused by interacting with sulfur- and phosphorous-containing compounds like DNA. The higher antibacterial activity of E. coli and S. aureus is probably driven by the difference in the structure of cell walls between gram-negative and gram-positive bacteria. The cell wall of gram-negative bacteria consists of lipids, proteins and lipopolysaccharides (LPS) that ensure more effective defense against biocides in comparison to gram-positive bacteria where the cell wall does not contain outer membrane of LPS [30, 31], thus leading to higher antibacterial activity of PVA-capped SNPs.
Table 1. The results of antibacterial activity with zone of inhibition.
| 1 | B. cereus | 0 mm | 10 mm | 15 mm | 20 mm |
| 2 | E. coli | 0 mm | 10 mm | 20 mm | 25 mm |
| 3 | S. aureus | 0 mm | 3 mm | 5 mm | 11 mm |
| 4 | P. vulgaris | 0 mm | 5 mm | 20 mm | 20 mm |
4. Conclusion
We report a facile method for the synthesis of PVA-capped SNPs. The absorption spectra confirm the presence of SPR at 410 nm, a characteristic of SNPs. The average particle size is 10–60 nm. PVA can be applied as a cheap and environmentally friendly biomaterial for synthesis of SNPs. The PVA-capped SNPs demonstrate anti-bacterial activity. This activity was tested against B. cereus, E. coli, S. aureus, P. vulgaris bacteria and the results shows very good antimicrobial activity. The silver nanoparticles produced in this manner have potential applications in the biomedical fields.
Acknowledgments
One of the authors (RSP) is grateful to Department of Chemistry, Shivaji University, Kolhapur and University Grants Commission, New Delhi for SAP Fellowship. We are also grateful to Department of Science and Technology, Government of India for DST-FIST programme facilities, Indian Institute of Technology, Bombay for TEM analysis. The authors gratefully acknowledge Department of Materials Science and Engineering, Chonnam National University, Gwangju, South Korea for characterization facilities.